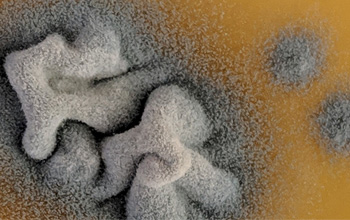

Uchafbwyntiau Ein Hymchwil
- Rydym (yn y 4ydd safle yn y DU) ymhlith y pump uchaf ar gyfer ansawdd yr ymchwil yn gyffredinol
- Rydym wedi cynnal ein safle ymhlith y pump uchaf oddi ar REF2014
- Cafwyd cynnydd yn y GPA cyffredinol o 3.49 i 3.53 oddi ar REF2014
- Cafodd 97% o'n hallbynnau ymchwil sgôr o 4/3
- Cafodd 48% o'n hallbynnau ymchwil sgôr o 4*
- Ystyrir bod 90% o'n heffaith yn arwain y byd ac yn rhagorol yn rhyngwladol; ystyrir bod 60% o'n heffaith yn arwain y byd
- Cafodd 100% o'n hamgylchedd ei asesu'n 4*/3* (h.y. yn ffafriol i gynhyrchu ymchwil o ansawdd sy'n arwain y byd, ac yn galluogi effaith o ran ei natur hanfodol a'i chynaliadwyedd)
- Cafodd 87.75% o'n hamgylchedd ei asesu'n 4* (h.y. yn ffafriol i gynhyrchu ymchwil o ansawdd sy'n arwain y byd, ac yn galluogi effaith o ran ei natur hanfodol a'i chynaliadwyedd)
- Mae'r incwm ymchwil wedi cynyddu o gyfanswm o £40.8 miliwn yn cael ei adrodd yn REF2014 i dros £94.6 miliwn yn cael ei adrodd yn REF2021 – cynnydd o 132%.
- Rydym wedi cynyddu ein carfan o ymchwilwyr ôl-raddedig o 60 yn 2013-2014 i 162 yn 2019-2020, sy'n gynnydd o 170%.
“Mae ein hymchwil, ac yn arbennig yr effaith a gawn ar y byd, mor bwysig i ni, ac mae gweld bod ein gwaith yn cael ei ystyried ymhlith y 10 uchaf yn y DU ar gyfer effaith sy'n arwain y byd, yn llwyddiant anhygoel ar gyfer ein maes ymchwil.”
Ein Gweledigaeth
Ein nod yw datblygu cyflenwad cynaliadwy o dalent ac amrywio ein portffolio ariannu trwy wneud y mwyaf o gyfleoedd ymchwil rhyngddisgyblaethol ar ffurf ymchwil ganolbwyntiedig sy'n ymateb i heriau materion iechyd byd-eang allweddol..
Ein Hamgylchedd
Mae Ysgol Feddygol Prifysgol Abertawe yn hyfforddi gwyddonwyr biofeddygol, fferyllwyr, meddygon cyswllt a meddygon y dyfodol mewn amgylchedd ymchwil cefnogol a chynhwysol. Mae’r amgylchedd hwn yn rhoi rhyddid i’n hymchwilwyr ymgymryd ag ymchwil ryngddisgyblaethol a chydweithredol, datblygu dulliau arloesol o ymdrin â phroblemau perthynol i iechyd, ac ehangu’r economi wybodaeth.
Ein Hallbynnau
O fewn cyfnod y Fframwaith Rhagoriaeth Ymchwil, rydym wedi cyhoeddi dros 2,500 o erthyglau cyfnodolion a adolygwyd gan gymheiriaid, lawer ohonynt o ganlyniad i Uned Asesu 3 Y Proffesiynau Perthynol i Iechyd, Deintyddiaeth, Nyrsio a Fferylliaeth gydweithio rhyngddisgyblaethol a byd-eang. Mae ein hallbynnau'n cael eu hadneuo'n rheolaidd yn yr ystorfa mynediad agored, CRONFA, a gynhelir gan y Brifysgol, sy'n eu gwneud yn hawdd eu darganfod, eu lawrlwytho a'u chwilio gan unrhyw un sydd â chysylltiad â'r Rhyngrwyd, ac yn rhad ac am ddim i'w darllen. Mae ein cymuned ymchwil ôl-raddedig yn gyfranwyr gweithredol, gyda 22% o’r papurau a ddewiswyd ar gyfer ein cyflwyniad REF2021 wedi eu hysgrifennu ar y cyd gan ein myfyrwyr.
Ein Heffaith
Mae ein strategaeth ymchwil yn rhoi pwyslais ar gael effaith yn y byd go iawn ar ymarfer clinigol, iechyd a llesiant trwy arloesi, technoleg a rhagoriaeth ymchwil. Mae ein hymchwil wedi bod yn ganolog i ehangu dealltwriaeth wyddonol o risgiau gwenwynegol nano-ddeunyddiau a rôl colesterol mewn iechyd dynol a chlefydau; o ran hwyluso datblygiad gwrthffwngau newydd; yn y defnydd o ddata mawr i drawsnewid dealltwriaeth, gofal a chanlyniadau o ran iechyd meddwl yn achos pobl ifanc; ac i osgoi ymyriadau meddygol costus a dianghenraid ar gyfer y GIG.
Ein Cymuned
Dewch i gwrdd â chymuned staff ac ôl-raddedig Ysgol Feddygol Prifysgol Abertawe